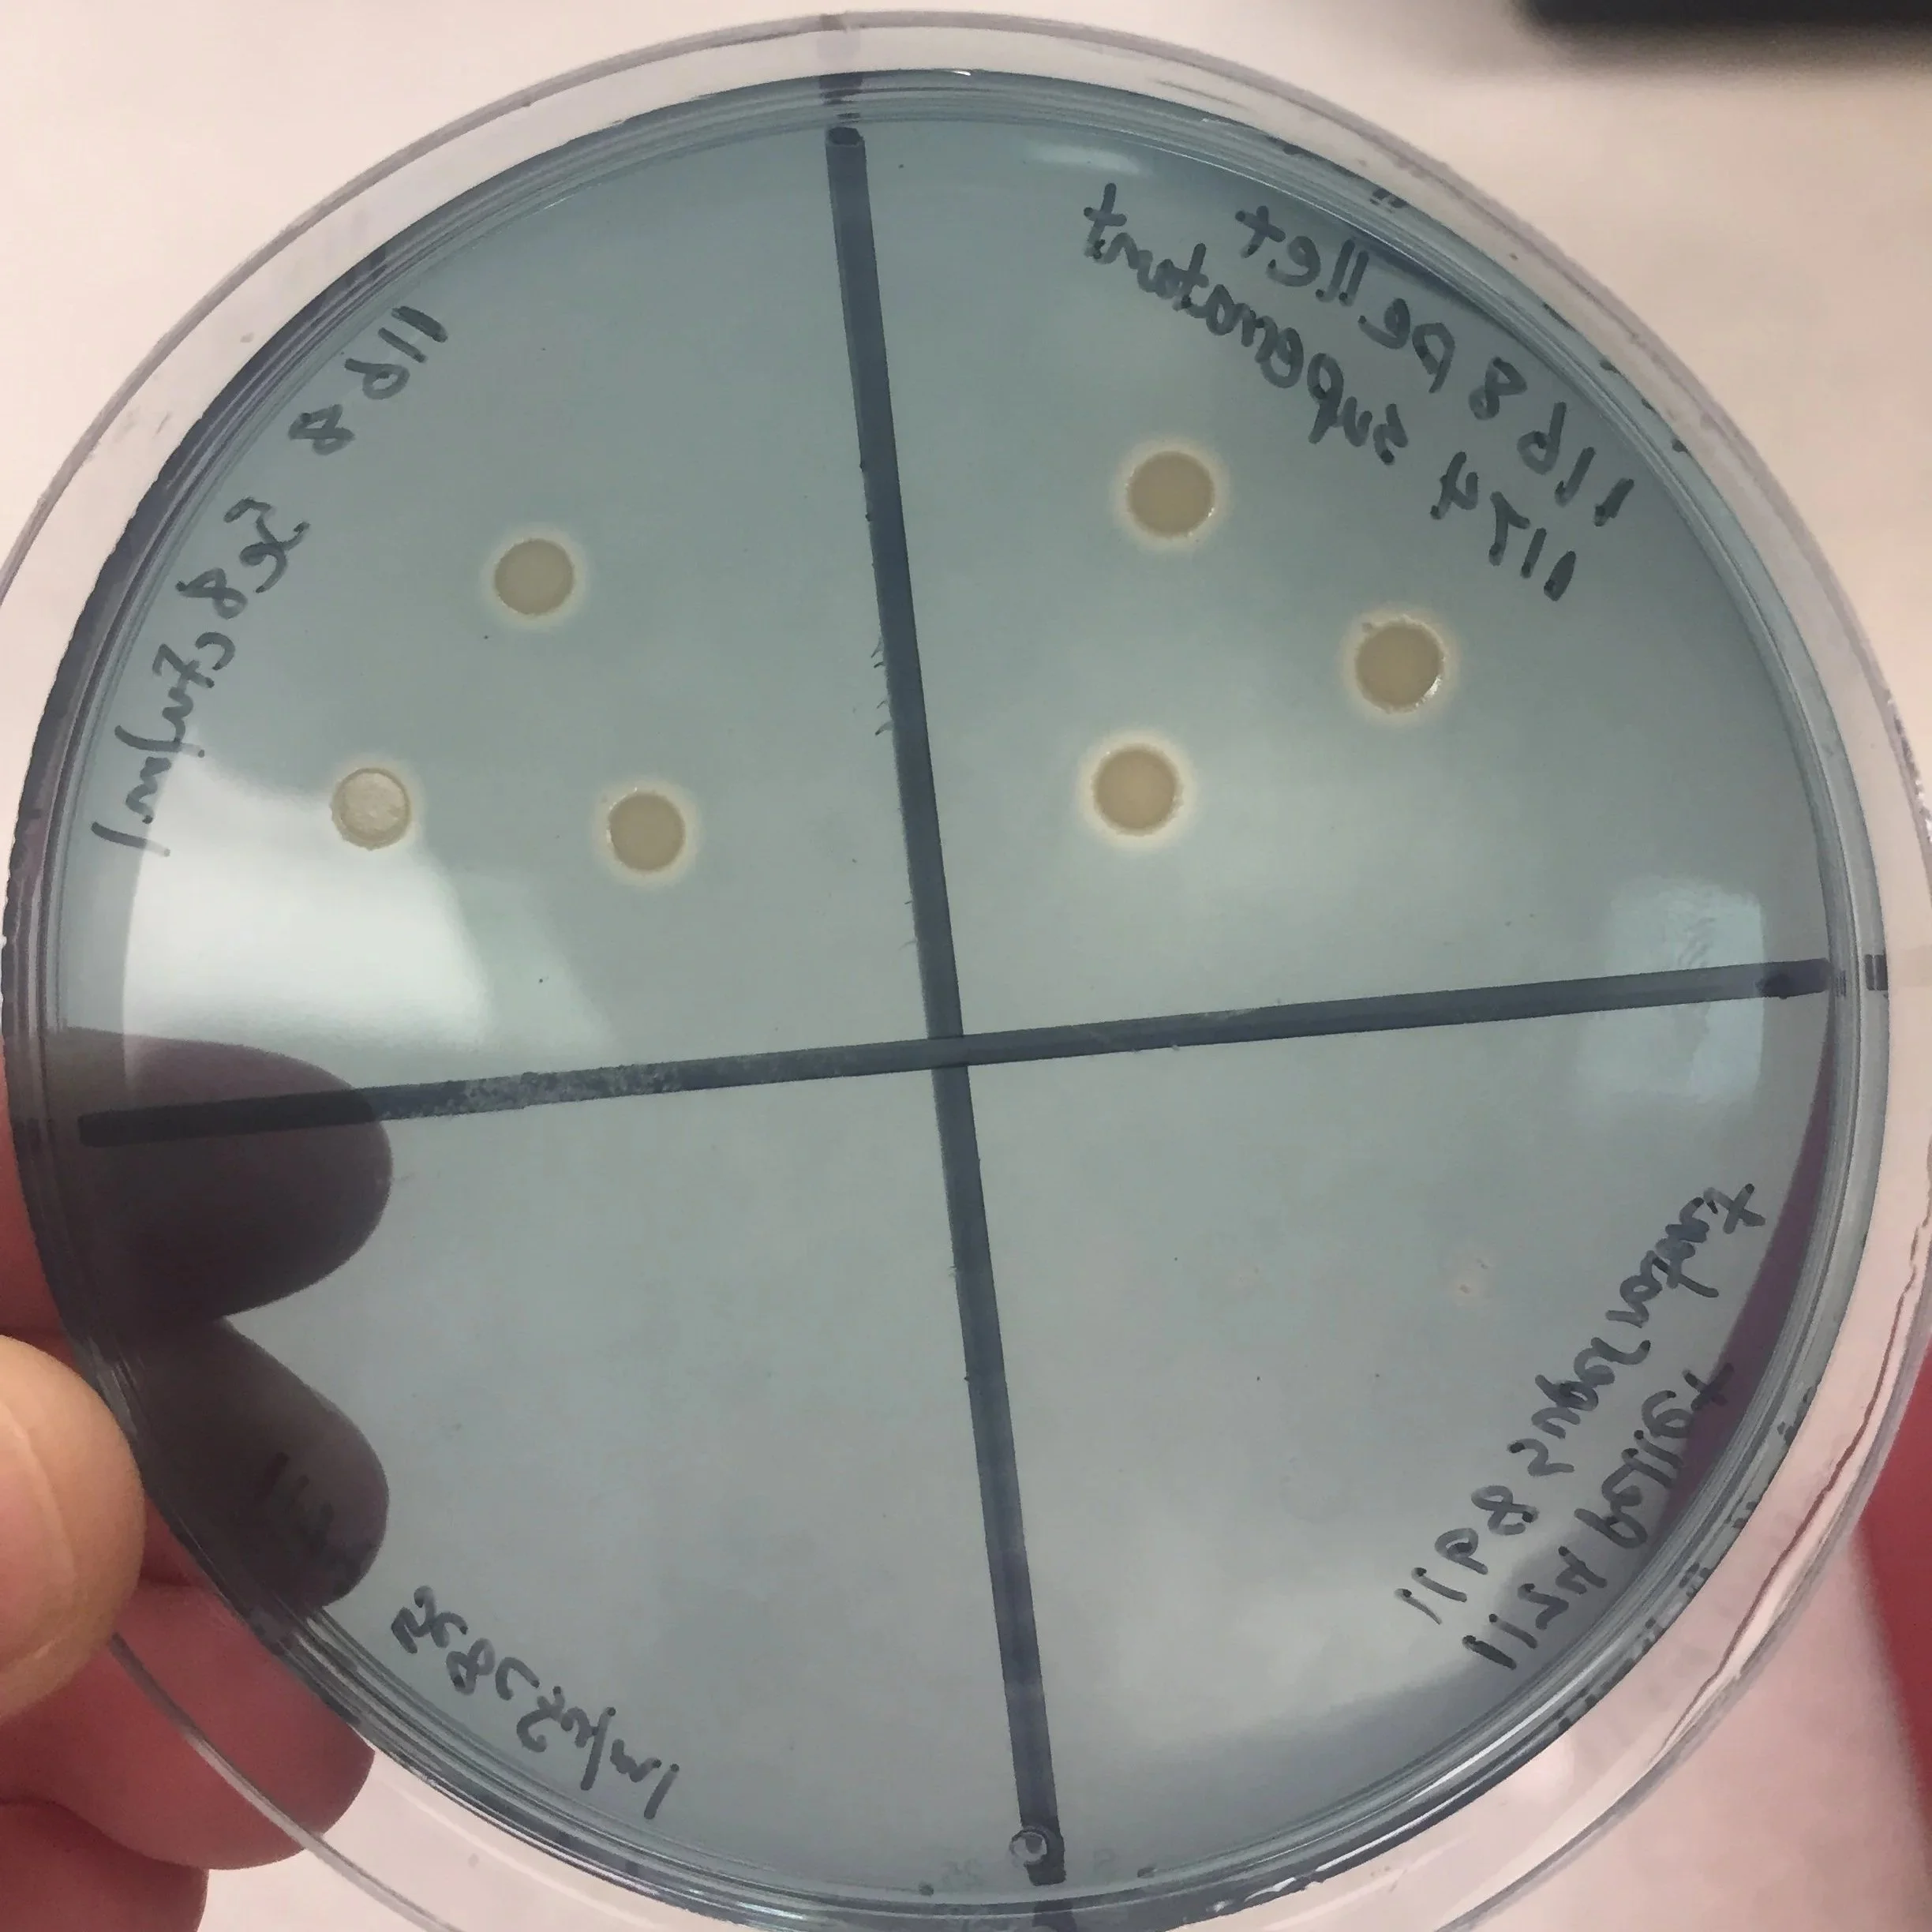

Biologicals Are Not Chemistry
Biological products rarely fail because the science is weak.
They fail because the industry is still trying to sell biology using a chemistry playbook.
TL;DR
Biological products are booming, but many fail to scale because the industry is still using a chemistry playbook to sell biology. Chemistry thrives on consistency. Biology operates in context. When companies launch biologicals with broad positioning, yield-only messaging, and nationwide ambitions, they dilute the very conditions that make the product work. The path forward is focus: solve a specific grower pain point, dominate a niche, and build commercialization strategies that respect the complexity of living systems.
Why the Agricultural Industry Is Still Using the Wrong Playbook for Biological Products
Ag biologicals will grow from 18.4 billion USD to almost 35 billion USD by 2030.
Why the Agricultural Industry Is Still Using the Wrong Playbook for Biological Products
Biological products are having their moment in Agriculture right now. Regen, sustainability, ESG, you name it, and biological products have found their home in those systems. And guess what, the industry is already saturated.
But Whitney, it’s estimated that we will grow from 18.4 billion USD to almost 35 billion USD by 2030…that doesn’t seem saturated to me. True, true, from a market potential point of view. But from a product differentiation perspective, we’re saturated with ‘me too’ products that only tout production effects and RIO. The Ag market can’t hold another generic biological product.
And yet, despite all of this innovation and market potential, something keeps happening once these products move from the lab into the marketplace. They stall and some ultimately fail.
But when I ask folks why they think biologicals fail I hear things like:
Farmers are skeptical.
It’s nothing but snake oil or pixie dust.
The sales team only wants to sell the easy product.
The sales team only wants to sell the next new product.
The market isn’t ready yet.
But after spending years working at the intersection of biological science, product development, and commercialization, I’ve noticed something else. The problem isn’t the science. It’s the playbook.
The Ag industry is still trying to scale biology using a chemistry mindset. One microbe, peptide, seaweed extract to rule them all (everywhere and on everything).
The Foundational Misunderstanding
For most of modern agriculture, chemistry has been the backbone of crop inputs.
Herbicides.
Fungicides.
Insecticides.
Synthetic fertilizers.
These tools transformed productivity and helped shape the way agricultural products are developed, marketed, and sold. And I’m not absolutely NOT against chemical inputs. But chemistry has one defining characteristic that quietly shaped the entire industry.
Chemistry behaves consistently.
A herbicide molecule behaves the same way in Iowa as it does in Illinois. A fungicide molecule behaves the same way in Kansas as it does in Indiana. And nitrogen makes any plant grow anywhere in the world.
Of course there are variables in agriculture. Weather, soil type, and management always play a role. But fundamentally, chemistry is built around a model of predictable performance, and consistency makes scaling easier. It makes the messaging easy. The science story almost writes itself.
When performance is predictable, companies can launch broadly. They can communicate simple claims, and they can focus their messaging around a single outcome (yield and ROI). And what that has built is an economies of scale US food production system.
The US produces extremely large volumes at an extremely low prices. So that means the gains we are striving for at this moment are miniscule compared to the gains 50-75 years ago when we first started using chemistries more ubiquitously.
But we are still communicating outcomes in terms of universal gains, when we need to be looking at the system from a margin’s perspective. We’ve brought the whole production system up, and now we get to produce differentiated products that tackle specific grower problems. And that is where I think biological products will thrive.
Because biological products operate inside living systems. A microbial product interacts with soil biology. It interacts with weather and crop physiology and management practices.
The same microbe may behave differently depending on soil organic matter, moisture conditions, or how the grower manages nitrogen. That doesn’t make biological products unreliable. It makes them contextual. And that distinction matters more than most product launch strategies currently acknowledge.
Chemistry is built for consistency.
Biology is built for context.
When companies try to scale biological products using assumptions built for chemistry, they unintentionally create friction at every stage of commercialization including product development.
Where Companies Go Wrong
The pattern is surprisingly consistent. A company discovers a promising microbial strain or derivative. Initial R&D testing looks promising, and the first field trials start to show yield responses.
Excitement builds internally.
The product moves forward.
Proof-of-concept trials expand into multi-location field trials. The R&D team generates strong efficacy data. Leadership begins to envision a broad commercial opportunity. And this is usually the point where the commercialization strategy starts to look very familiar.
They have 2-3 years of field trials. They have a solid yield increase and ROI message. And then they launch – everywhere.
On paper, it seems logical. Yield is the universal language of agriculture. But something subtle happens when yield becomes the entire story.
The farmers of today are overlaying your biological product on top of 70 years of chemistry foundations. They are inserting a biology-based play into a chemistry-based playbook. And they don’t get it. It doesn’t compute. It’s like trying to run a soccer play in an American football game. Yes they might both be called ‘futbol,’ but they are totally different.
So growers stop being able to ‘see’ themselves using the biology-based product. They don’t know where it fits into their management practices. They need to know things like what exactly is this microbe doing?
Is it fixing nitrogen?
Stimulating root growth?
Improving nutrient availability?
Under what conditions should I expect to see this response?
How does it interact with the rest of my fertility program?
These questions are not obstacles. They are signs of engagement. Growers want to understand how to leverage biology to give them a leg up. To help increase their margins.
But too often the product launch strategy hasn’t prepared the sales team to answer these types of questions clearly. We have a whole group of sales people wanting to transition to biology-based products, but they don’t get the training needed to drop the old playbook and adopt a new one.
When companies position a biological product as universally applicable across crops, geographies, and management systems, they unintentionally dilute the very context that makes the product work. A one-size-fits-all biological is a one-size-fits-none.
Sales teams struggle to explain product benefits clearly, growers struggle to understand when it fits their system, and ultimately the product never quite achieves the market traction leadership expected.
The Scaling Problem
This challenge becomes even more visible when companies begin thinking about scale. They realize they need more revenue to sustain their business so they do what any good chemistry company has done over the past 50 years - push toward broad acreage as quickly as possible.
In row crops, it’s Midwest corn.
If a product can capture even a small percentage of that market, the thinking goes, the revenue potential is enormous. But large markets create large expectations and large competition.
Biological products should be designed to solve specific problems in specific systems, and my argument is that Midwest corn needs the least amount of help reaching their maximum yield potential.
Here’s the important part. When companies chase acreage too early, they often spread resources thin across too many geographies. Marketing budgets stretch across dozens of states. Sales teams try to explain the product in vastly different cropping systems with very little real-world data in their region to support these claims. Field trial data becomes harder to interpret because environmental conditions vary so widely.
So, instead of building strong adoption in a focused area, the company ends up creating small pockets of awareness everywhere. I call it the shotgun approach. A smattering of buyers scattered across a huge geographic footprint.
Biology is a precision tool. Think rifle instead of shotgun. A rifle approach concentrates effort in a place where the product has a clear advantage. Early traction in biological products usually comes from niche dominance.
A specific crop.
A specific region.
A specific production challenge.
When companies attempt to launch everywhere at once, they often miss the opportunity to establish that early stronghold. Instead of dominating a niche, they become one more product on a crowded shelf.
What Needs to Change
None of these challenges are inevitable and can be overcome by challenging assumptions that have been carried over from the chemistry era of agriculture.
The solution is not to simplify biology until it resembles chemistry. The solution is to respect the complexity of biology and design commercialization strategies around it.
That starts with asking better questions earlier in product development. What problem are we actually solving? Not in theory. In practice.
What pain point does this product address for a grower?
Is it nutrient efficiency?
Early root development?
Stress tolerance?
Is it clogged fertigation lines?
Is it algae build-up in your tanks?
Once that problem is clear, the next questions become easier to answer.
1. In which crop is that pain point most visible?
2. In which region does it occur most consistently?
3. Under what management practices does the product perform best?
4. Which growers are most likely to recognize the value immediately?
These questions narrow the launch strategy in ways that often feel uncomfortable at first. It’s going to feel like you are leaving money on the table. But I promise you, you are not. By not going narrow enough, you don’t even have a table for the money to be left on.
Focus creates clarity, and clarity creates confidence.
Dominate a niche first, then using revenue from the first niche, expand into another. Rinse and repeat.
My Point of View
Over the years I’ve worked with scientists, founders, and sales teams across biological agriculture, I’ve developed a few opinions that guide how I think about these products.
Stop chasing the money —> Chase the pain point.
When companies start with the size of the market instead of the severity of the problem, the strategy often drifts toward broad positioning and diluted messaging. It also results in ping-ponging around for 4 years and never developing a viable product.
Stop launching everywhere —> Focus builds momentum —> Momentum builds credibility.
Credibility travels faster than marketing budgets ever will. Agriculture is an incredibly small industry. Once you fail, it’s near impossible to bounce back. So go slow, build trust. When you mess up, own it with the few early adopters and make it right. It’s not about perfection, it’s about trust.
Stop hiding the science.
There is a persistent belief in parts of the industry that explaining biological mechanisms will overwhelm growers. “People want simple.” In my experience, the opposite is true. Farmers are deeply curious about how things work, and come on people, they manage complex biological systems every day. They are typically highly educated and have YEARS if not DECADES of experience. They want real answers, and science doesn’t have to be complicated. I think it’s just an excuse so that companies don’t have to put the work into creating the systems that enable their sales team to actually sell products.
The Future of Biological Agriculture
Biological products have enormous potential in agriculture. They can help improve nutrient efficiency, support soil health, reduce input dependency, and unlock new ways of managing crop systems. But realizing that potential requires a shift in how the industry thinks about commercialization.
Biology will not scale using the same playbook that scaled chemistry. It requires a deeper understanding of context and demands focus before expansion. Because while the science behind biologicals continues to advance rapidly, the commercial playbook for scaling them is still being written.
The companies that win in BioAg will not be the ones with the most microbes. They will be the ones with the right commercialization strategy.